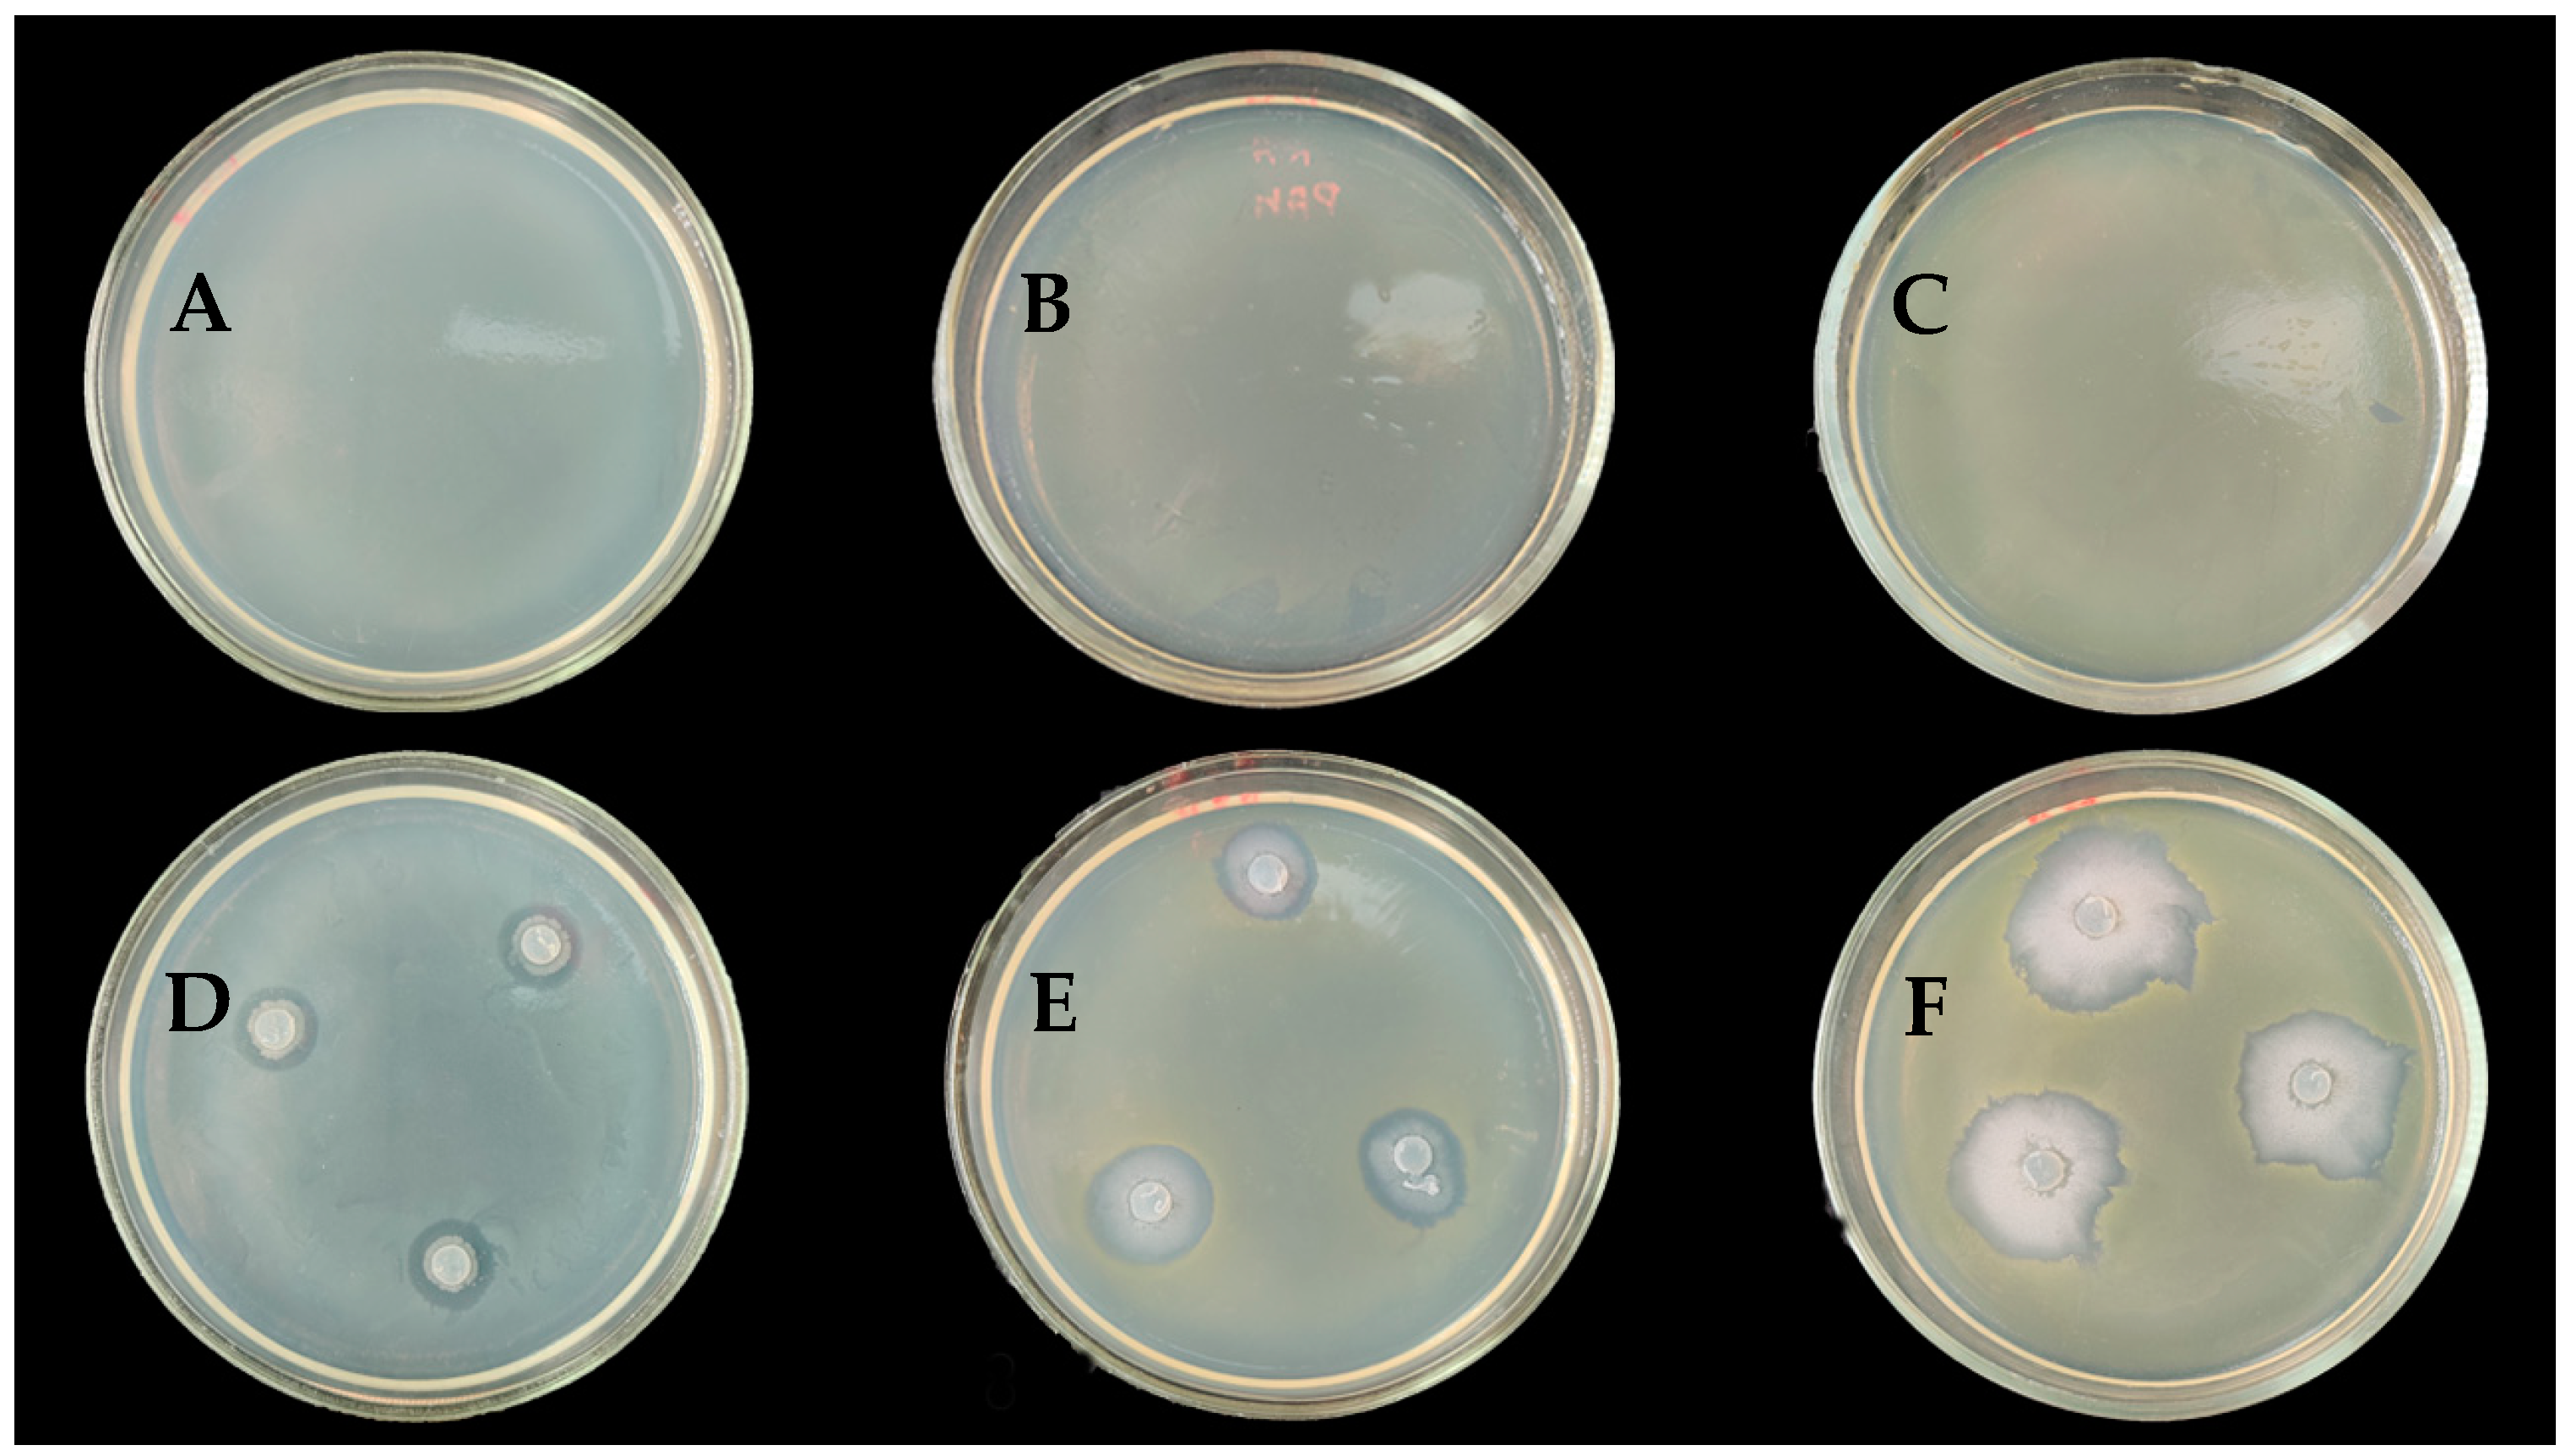
Microorganisms 12 01533 g001
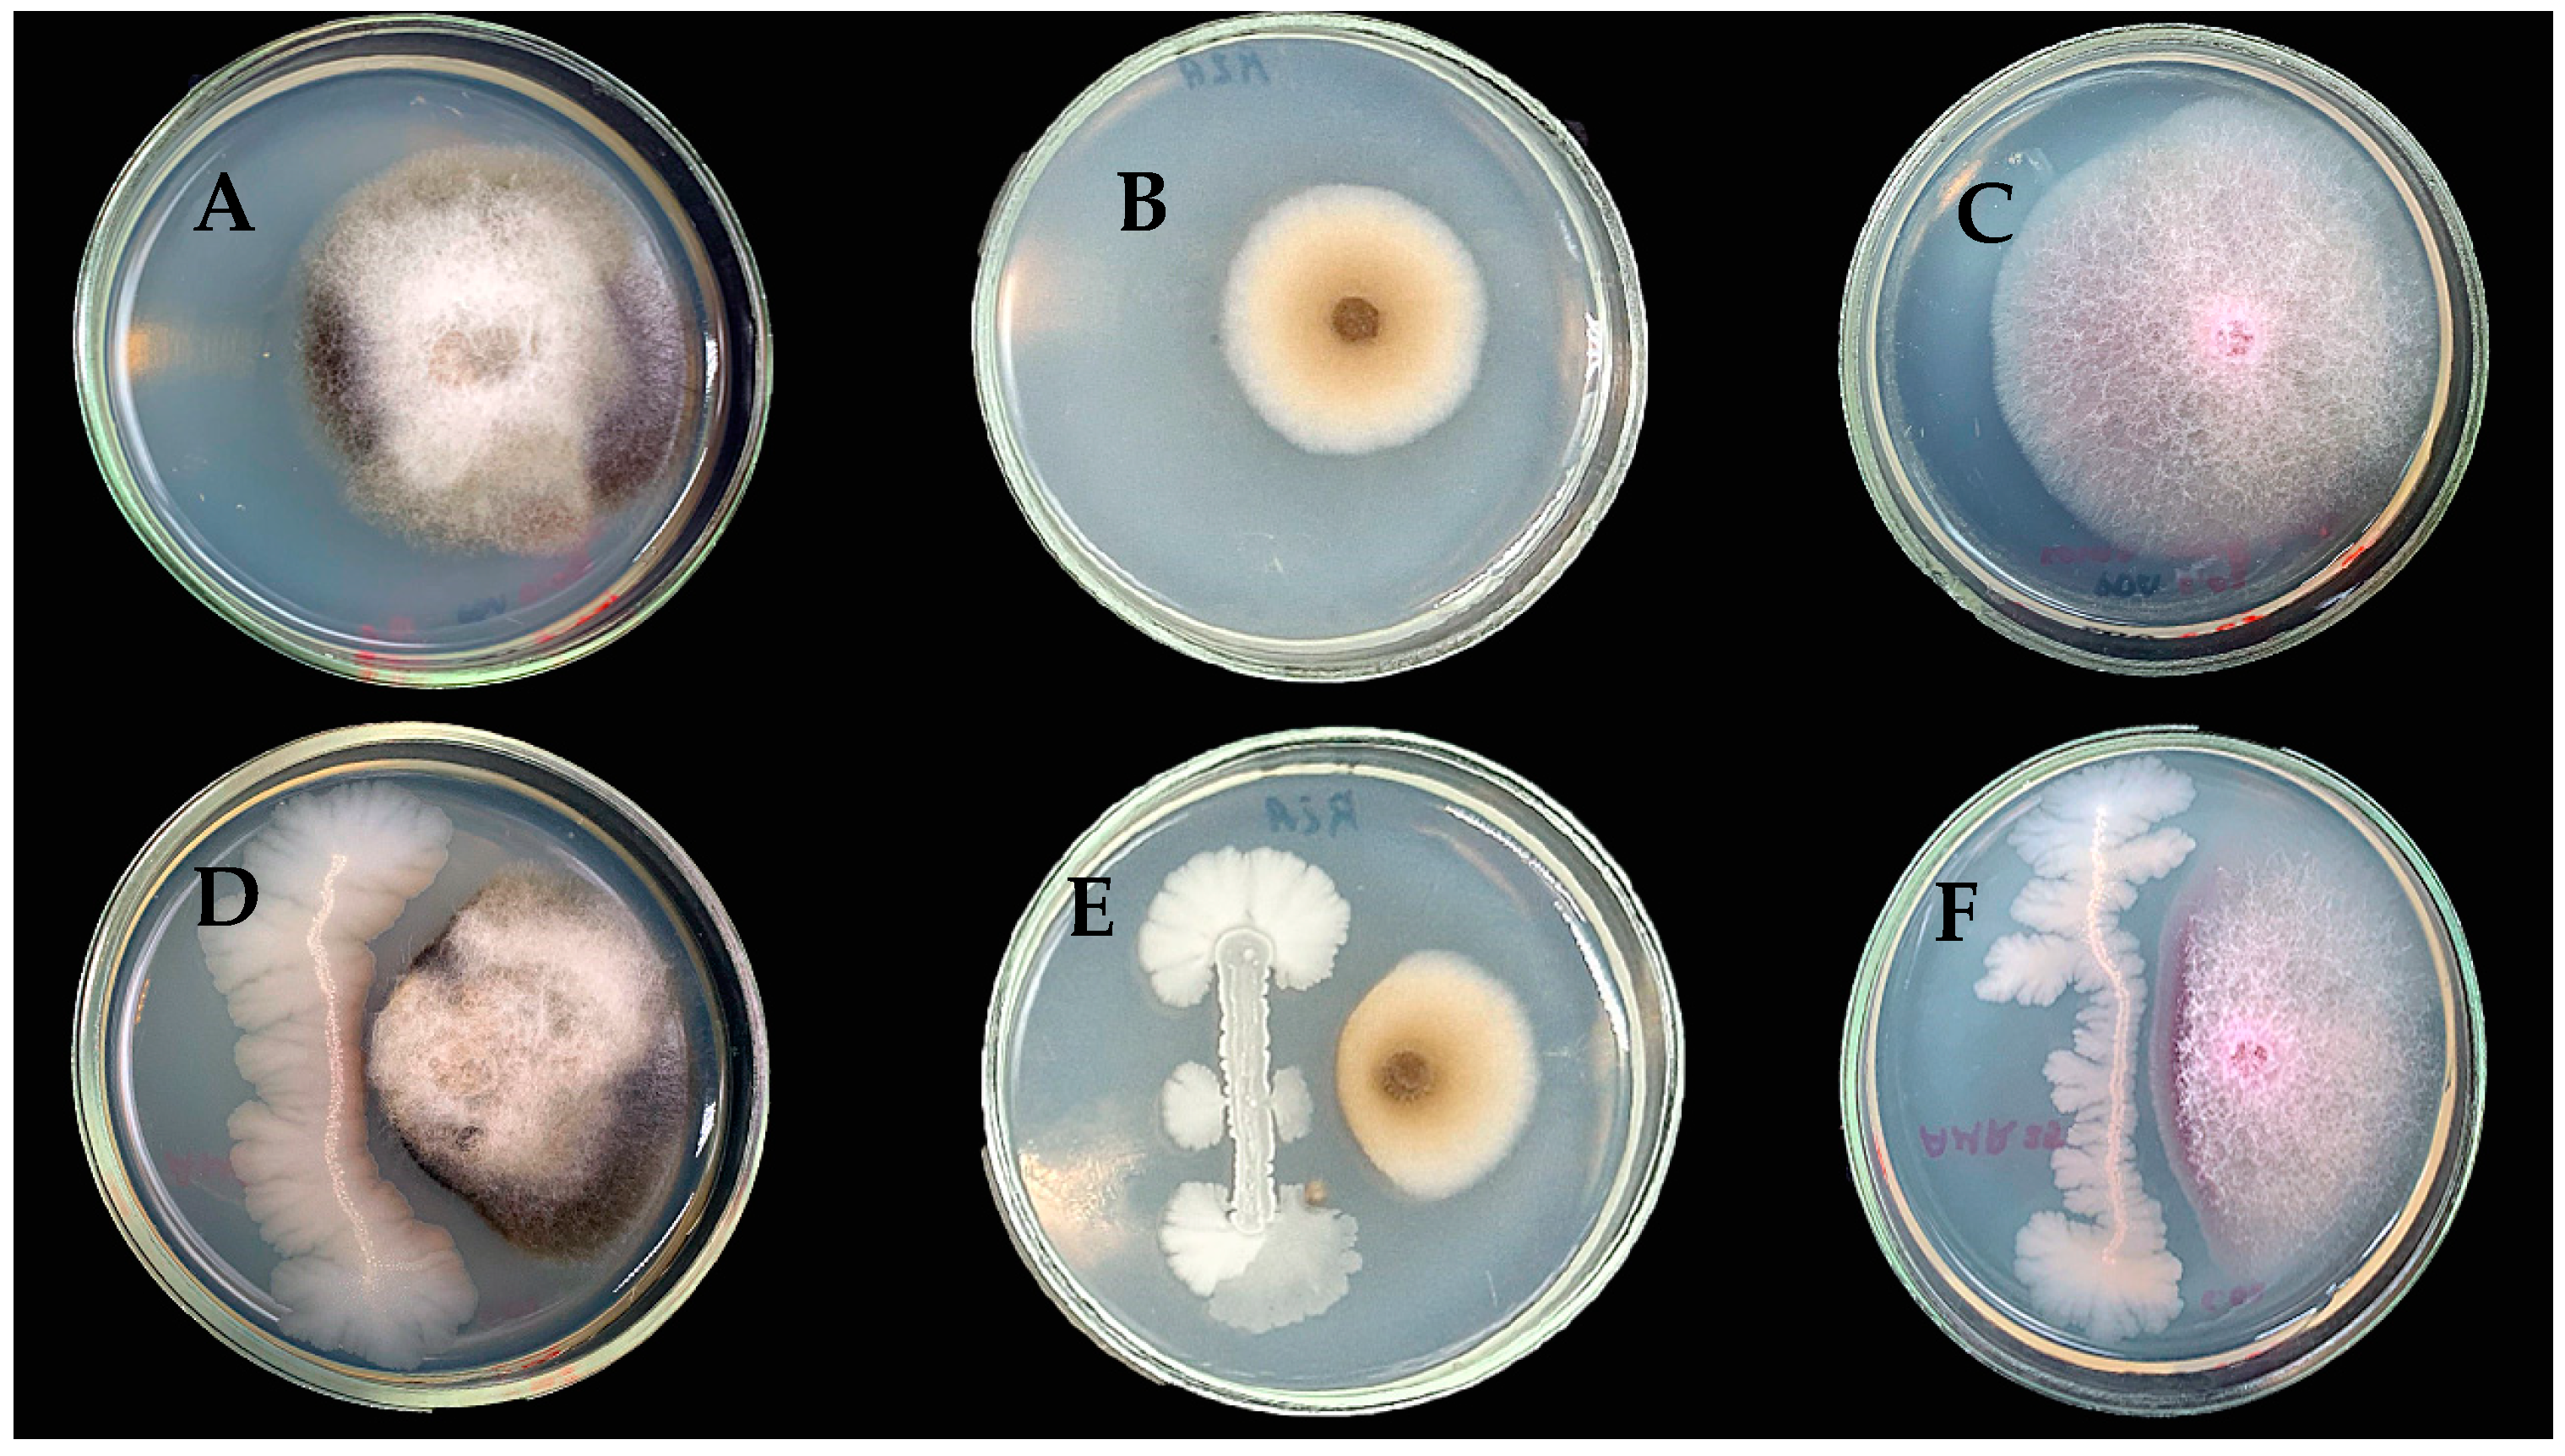
Microorganisms 12 01533 g002

Whole Genome Sequencing of Bacillus velezensis AMR25, an Effective Antagonist Strain against Plant Pathogens
Abstract
1. Introduction
2. Materials and Methods
2.1. Bacterial Strains
2.2. Antagonism of Bacillus velezensis AMR25 on Petri Plates
2.3. Antibiotic Resistance Analysis of Bacillus velezensis AMR25
2.4. Genome Sequencing, Assembly and Annotation of Bacillus velezensis AMR25
2.5. Phylogenetic Analysis
2.6. Analysis of Average Nucleotide Identity
2.7. Comparative Genomics
2.8. Secondary Metabolites Analysis
3. Results
3.1. Antipathogenic Activity of Bacillus velezensis AMR25
3.2. Genome Features
3.3. Phylogenetic Analysis of Bacillus velezensis AMR25
3.4. Comparison of Genetic Characteristics of Differentd Bacillus Strains
3.5. Gene Clusters of Antipathogenic Activity Identified in the Genome of Bacillus velezensis AMR25
3.6. Antibiotic Resistance Testing Endophytic Bacteria Bacillus velezensis AMR25
3.7. Genetic Elements of Bacillus velezensis AMR25 Responsible for Plant-Bacterial Interaction
3.7.1. IAA Products
3.7.2. Cytokinin Products
3.7.3. Nutrient Acquisition
3.7.4. Motility, Chemotaxis and Adhesion of Plants
4. Discussion
5. Conclusions
Supplementary Materials
Author Contributions
Funding
Informed Consent Statement
Data Availability Statement
Conflicts of Interest
References
- De Coninck, B.; Timmermans, P.; Vos, C.; Cammue, B.P.A.; Kazan, K. What Lies beneath: Belowground Defense Strategies in Plants. Trends Plant Sci. 2015, 20, 91–101. [Google Scholar] [CrossRef]
- Abbey, J.A.; Percival, D.; Abbey, L.; Asiedu, S.K.; Prithiviraj, B.; Schilder, A. Biofungicides as Alternative to Synthetic Fungicide Control of Grey Mould (Botrytis cinerea)—Prospects and Challenges. Biocontrol Sci. Technol. 2019, 29, 207–228. [Google Scholar] [CrossRef]
- Roca-Couso, R.; Flores-Félix, J.D.; Rivas, R. Mechanisms of Action of Microbial Biocontrol Agents against Botrytis cinerea. J. Fungi 2021, 7, 1045. [Google Scholar] [CrossRef]
- Lugtenberg, B.J.J.; Caradus, J.R.; Johnson, L.J. Fungal Endophytes for Sustainable Crop Production. FEMS Microbiol. Ecol. 2016, 92, fiw194. [Google Scholar] [CrossRef] [PubMed]
- Nair, D.N.; Padmavathy, S. Impact of Endophytic Microorganisms on Plants, Environment and Humans. Sci. World J. 2014, 2014, 250693. [Google Scholar] [CrossRef]
- Chowdhury, S.P.; Uhl, J.; Grosch, R.; Alquéres, S.; Pittroff, S.; Dietel, K.; Schmitt-Kopplin, P.; Borriss, R.; Hartmann, A. Cyclic Lipopeptides of Bacillus amyloliquefaciens Subsp. Plantarum Colonizing the Lettuce Rhizosphere Enhance Plant Defense Responses Toward the Bottom Rot Pathogen Rhizoctonia solani. Mol. Plant-Microbe Interact. 2015, 28, 984–995. [Google Scholar] [CrossRef]
- Santoyo, G.; Moreno-Hagelsieb, G.; del Carmen Orozco-Mosqueda, M.; Glick, B.R. Plant Growth-Promoting Bacterial Endophytes. Microbiol. Res. 2016, 183, 92–99. [Google Scholar] [CrossRef]
- Nicot, P.C.; Stewart, A.; Bardin, M.; Elad, Y. Biological Control and Biopesticide Suppression of Botrytis-Incited Diseases. In Botrytis—The Fungus, the Pathogen and Its Management in Agricultural Systems; Fillinger, S., Elad, Y., Eds.; Springer International Publishing: Cham, Switzerland, 2016; pp. 165–187. ISBN 978-3-319-23371-0. [Google Scholar]
- Khare, E.; Mishra, J.; Arora, N.K. Multifaceted Interactions Between Endophytes and Plant: Developments and Prospects. Front. Microbiol. 2018, 9, 2732. [Google Scholar] [CrossRef]
- Bhattacharyya, P.N.; Jha, D.K. Plant Growth-Promoting Rhizobacteria (PGPR): Emergence in Agriculture. World J. Microbiol. Biotechnol. 2012, 28, 1327–1350. [Google Scholar] [CrossRef]
- Amarouchi, Z.; Esmaeel, Q.; Sanchez, L.; Jacquard, C.; Hafidi, M.; Vaillant-Gaveau, N.; Ait Barka, E. Beneficial Microorganisms to Control the Gray Mold of Grapevine: From Screening to Mechanisms. Microorganisms 2021, 9, 1386. [Google Scholar] [CrossRef]
- Ongena, M.; Jacques, P. Bacillus Lipopeptides: Versatile Weapons for Plant Disease Biocontrol. Trends Microbiol. 2008, 16, 115–125. [Google Scholar] [CrossRef] [PubMed]
- Palazzini, J.M.; Dunlap, C.A.; Bowman, M.J.; Chulze, S.N. Bacillus velezensis RC 218 as a Biocontrol Agent to Reduce Fusarium Head Blight and Deoxynivalenol Accumulation: Genome Sequencing and Secondary Metabolite Cluster Profiles. Microbiol. Res. 2016, 192, 30–36. [Google Scholar] [CrossRef] [PubMed]
- Fazle Rabbee, M.; Baek, K.-H. Antimicrobial Activities of Lipopeptides and Polyketides of Bacillus velezensis for Agricultural Applications. Molecules 2020, 25, 4973. [Google Scholar] [CrossRef] [PubMed]
- Xia, L.; Wen, J. Available Strategies for Improving the Biosynthesis of Surfactin: A Review. Crit. Rev. Biotechnol. 2023, 43, 1111–1128. [Google Scholar] [CrossRef] [PubMed]
- Zhou, D.; Hu, F.; Lin, J.; Wang, W.; Li, S. Genome and Transcriptome Analysis of Bacillus velezensis BS-37, an Efficient Surfactin Producer from Glycerol, in Response to D-/L-leucine. MicrobiologyOpen 2019, 8, e00794. [Google Scholar] [CrossRef] [PubMed]
- Wang, G.F.; Meng, J.F.; Tian, T.; Xiao, X.Q.; Zhang, B.; Xiao, Y.N. Endophytic Bacillus velezensis Strain B-36 Is a Potential Biocontrol Agent against Lotus Rot Caused by Fusarium oxysporum. J. Appl. Microbiol. 2020, 128, 1153–1162. [Google Scholar] [CrossRef] [PubMed]
- Cao, Y.; Pi, H.; Chandrangsu, P.; Li, Y.; Wang, Y.; Zhou, H.; Xiong, H.; Helmann, J.D.; Cai, Y. Antagonism of Two Plant-Growth Promoting Bacillus velezensis Isolates Against Ralstonia Solanacearum and Fusarium Oxysporum. Sci. Rep. 2018, 8, 4360. [Google Scholar] [CrossRef] [PubMed]
- Xu, S.; Xie, X.; Zhao, Y.; Shi, Y.; Chai, A.; Li, L.; Li, B. Whole-Genome Analysis of Bacillus velezensis ZF2, a Biocontrol Agent That Protects Cucumis Sativus against Corynespora Leaf Spot Diseases. 3 Biotech 2020, 10, 186. [Google Scholar] [CrossRef] [PubMed]
- Pérez-García, A.; Romero, D.; de Vicente, A. Plant Protection and Growth Stimulation by Microorganisms: Biotechnological Applications of Bacilli in Agriculture. Curr. Opin. Biotechnol. 2011, 22, 187–193. [Google Scholar] [CrossRef]
- Aleynova, O.A.; Nityagovsky, N.N.; Ananev, A.A.; Suprun, A.R.; Ogneva, Z.V.; Dneprovskaya, A.A.; Beresh, A.A.; Tyunin, A.P.; Dubrovina, A.S.; Kiselev, K.V. The Endophytic Microbiome of Wild Grapevines Vitis amurensis Rupr. and Vitis coignetiae Pulliat Growing in the Russian Far East. Plants 2023, 12, 2952. [Google Scholar] [CrossRef]
- Leska, A.; Nowak, A.; Szulc, J.; Motyl, I.; Czarnecka-Chrebelska, K.H. Antagonistic Activity of Potentially Probiotic Lactic Acid Bacteria against Honeybee (Apis mellifera L.) Pathogens. Pathogens 2022, 11, 1367. [Google Scholar] [CrossRef]
- Lane, D. 16S/23S RRNA Sequencing. In Nucleic Acid Techniques in Bacterial Systematics; Wiley: Hoboken, NJ, USA, 1991; pp. 115–175. [Google Scholar]
- Romero-Severson, J.; Moran, T.E.; Shrader, D.G.; Fields, F.R.; Pandey-Joshi, S.; Thomas, C.L.; Palmer, E.C.; Shrout, J.D.; Pfrender, M.E.; Lee, S.W. A Seed-Endophytic Bacillus safensis Strain with Antimicrobial Activity Has Genes for Novel Bacteriocin-Like Antimicrobial Peptides. Front. Microbiol. 2021, 12, 734216. [Google Scholar] [CrossRef]
- White, T.J.; Bruns, T.; Lee, S.; Taylor, J. Amplification and Direct Sequencing of Fungal Ribosomal RNA Genes for Phylogenetics. In PCR Protocols; Innis, M.A., Gelfand, D.H., Sninsky, J.J., White, T.J., Eds.; Academic Press: San Diego, CA, USA, 1990; pp. 315–322. ISBN 978-0-12-372180-8. [Google Scholar]
- Mirsam, H.; Suriani; Aqil, M.; Azrai, M.; Efendi, R.; Muliadi, A.; Sembiring, H.; Azis, A.I. Molecular Characterization of Indigenous Microbes and Its Potential as a Biological Control Agent of Fusarium Stem Rot Disease (Fusarium verticillioides) on Maize. Heliyon 2022, 8, e11960. [Google Scholar] [CrossRef]
- Humphries, R.; Bobenchik, A.M.; Hindler, J.A.; Schuetz, A.N. Overview of Changes to the Clinical and Laboratory Standards Institute Performance Standards for Antimicrobial Susceptibility Testing, M100, 31st Edition. J. Clin. Microbiol. 2021, 59, e00213-21. [Google Scholar] [CrossRef]
- Echt, C.S.; Erdahl, L.A.; McCoy, T.J. Genetic Segregation of Random Amplified Polymorphic DNA in Diploid Cultivated Alfalfa. Genome 1992, 35, 84–87. [Google Scholar] [CrossRef]
- Wick, R.R.; Judd, L.M.; Gorrie, C.L.; Holt, K.E. Unicycler: Resolving Bacterial Genome Assemblies from Short and Long Sequencing Reads. PLoS Comput. Biol. 2017, 13, e1005595. [Google Scholar] [CrossRef]
- Seppey, M.; Manni, M.; Zdobnov, E.M. BUSCO: Assessing Genome Assembly and Annotation Completeness. Methods Mol. Biol. Clifton NJ 2019, 1962, 227–245. [Google Scholar] [CrossRef]
- Huerta-Cepas, J.; Forslund, K.; Coelho, L.P.; Szklarczyk, D.; Jensen, L.J.; von Mering, C.; Bork, P. Fast Genome-Wide Functional Annotation through Orthology Assignment by EggNOG-Mapper. Mol. Biol. Evol. 2017, 34, 2115–2122. [Google Scholar] [CrossRef]
- Altschul, S.F.; Gish, W.; Miller, W.; Myers, E.W.; Lipman, D.J. Basic Local Alignment Search Tool. J. Mol. Biol. 1990, 215, 403–410. [Google Scholar] [CrossRef]
- Riesco, R.; Carro, L.; Román-Ponce, B.; Prieto, C.; Blom, J.; Klenk, H.-P.; Normand, P.; Trujillo, M.E. Defining the Species Micromonospora saelicesensis and Micromonospora noduli Under the Framework of Genomics. Front. Microbiol. 2018, 9, 1360. [Google Scholar] [CrossRef]
- Lee, I.; Ouk Kim, Y.; Park, S.-C.; Chun, J. OrthoANI: An Improved Algorithm and Software for Calculating Average Nucleotide Identity. Int. J. Syst. Evol. Microbiol. 2016, 66, 1100–1103. [Google Scholar] [CrossRef]
- Arndt, D.; Grant, J.R.; Marcu, A.; Sajed, T.; Pon, A.; Liang, Y.; Wishart, D.S. PHASTER: A Better, Faster Version of the PHAST Phage Search Tool. Nucleic Acids Res. 2016, 44, W16–W21. [Google Scholar] [CrossRef]
- Alikhan, N.-F.; Petty, N.K.; Ben Zakour, N.L.; Beatson, S.A. BLAST Ring Image Generator (BRIG): Simple Prokaryote Genome Comparisons. BMC Genom. 2011, 12, 402. [Google Scholar] [CrossRef]
- Alcock, B.P.; Huynh, W.; Chalil, R.; Smith, K.W.; Raphenya, A.R.; Wlodarski, M.A.; Edalatmand, A.; Petkau, A.; Syed, S.A.; Tsang, K.K.; et al. CARD 2023: Expanded Curation, Support for Machine Learning, and Resistome Prediction at the Comprehensive Antibiotic Resistance Database. Nucleic Acids Res. 2022, 51, D690–D699. [Google Scholar] [CrossRef] [PubMed]
- Blin, K.; Shaw, S.; Augustijn, H.E.; Reitz, Z.L.; Biermann, F.; Alanjary, M.; Fetter, A.; Terlouw, B.R.; Metcalf, W.W.; Helfrich, E.J.N.; et al. AntiSMASH 7.0: New and Improved Predictions for Detection, Regulation, Chemical Structures and Visualisation. Nucleic Acids Res. 2023, 51, W46–W50. [Google Scholar] [CrossRef]
- Sun, J.; Lu, F.; Luo, Y.; Bie, L.; Xu, L.; Wang, Y. OrthoVenn3: An Integrated Platform for Exploring and Visualizing Orthologous Data across Genomes. Nucleic Acids Res. 2023, 51, W397–W403. [Google Scholar] [CrossRef]
- Cozzarelli, N.R. DNA Gyrase and the Supercoiling of DNA. Science 1980, 207, 953–960. [Google Scholar] [CrossRef]
- Chun, J.; Bae, K.S. Phylogenetic Analysis of Bacillus subtilis and Related Taxa Based on Partial GyrA Gene Sequences. Antonie Van Leeuwenhoek 2000, 78, 123–127. [Google Scholar] [CrossRef]
- Ménard, A.; Buissonnière, A.; Prouzet-Mauléon, V.; Sifré, E.; Mégraud, F. The GyrA Encoded Gene: A Pertinent Marker for the Phylogenetic Revision of Helicobacter Genus. Syst. Appl. Microbiol. 2016, 39, 77–87. [Google Scholar] [CrossRef]
- Dunlap, C.A.; Kwon, S.-W.; Rooney, A.P.; Kim, S.-J. Bacillus paralicheniformis Sp. Nov., Isolated from Fermented Soybean Paste. Int. J. Syst. Evol. Microbiol. 2015, 65, 3487–3492. [Google Scholar] [CrossRef]
- Grigoreva, A.; Andreeva, J.; Bikmetov, D.; Rusanova, A.; Serebryakova, M.; Garcia, A.H.; Slonova, D.; Nair, S.K.; Lippens, G.; Severinov, K.; et al. Identification and Characterization of Andalusicin: N-Terminally Dimethylated Class III Lantibiotic from Bacillus thuringiensis Sv. Andalousiensis. iScience 2021, 24, 102480. [Google Scholar] [CrossRef]
- Xiong, H.; Li, Y.; Cai, Y.; Cao, Y.; Wang, Y. Isolation of Bacillus amyloliquefaciens JK6 and Identification of Its Lipopeptides Surfactin for Suppressing Tomato Bacterial Wilt. RSC Adv. 2015, 5, 82042–82049. [Google Scholar] [CrossRef]
- Chen, X.H.; Scholz, R.; Borriss, M.; Junge, H.; Mögel, G.; Kunz, S.; Borriss, R. Difficidin and Bacilysin Produced by Plant-Associated Bacillus amyloliquefaciens Are Efficient in Controlling Fire Blight Disease. J. Biotechnol. 2009, 140, 38–44. [Google Scholar] [CrossRef]
- Romero-Tabarez, M.; Jansen, R.; Sylla, M.; Lünsdorf, H.; Häußler, S.; Santosa, D.A.; Timmis, K.N.; Molinari, G. 7-O-Malonyl Macrolactin A, a New Macrolactin Antibiotic from Bacillus Subtilis Active against Methicillin-Resistant Staphylococcus aureus, Vancomycin-Resistant Enterococci, and a Small-Colony Variant of Burkholderia Cepacia. Antimicrob. Agents Chemother. 2006, 50, 1701–1709. [Google Scholar] [CrossRef]
- Zeriouh, H.; Romero, D.; García-Gutiérrez, L.; Cazorla, F.M.; de Vicente, A.; Pérez-García, A. The Iturin-like Lipopeptides Are Essential Components in the Biological Control Arsenal of Bacillus subtilis Against Bacterial Diseases of Cucurbits. Mol. Plant-Microbe Interact. 2011, 24, 1540–1552. [Google Scholar] [CrossRef]
- Toral, L.; Rodríguez, M.; Béjar, V.; Sampedro, I. Antifungal Activity of Lipopeptides from Bacillus XT1 CECT 8661 Against Botrytis cinerea. Front. Microbiol. 2018, 9, 1315. [Google Scholar] [CrossRef]
- Pajčin, I.; Vlajkov, V.; Frohme, M.; Grebinyk, S.; Grahovac, M.; Mojićević, M.; Grahovac, J. Pepper Bacterial Spot Control by Bacillus velezensis: Bioprocess Solution. Microorganisms 2020, 8, 1463. [Google Scholar] [CrossRef]
- Chen, M.C.; Wang, J.P.; Zhu, Y.J.; Liu, B.; Yang, W.J.; Ruan, C.Q. Antibacterial Activity against Ralstonia Solanacearum of the Lipopeptides Secreted from the Bacillus amyloliquefaciens Strain FJAT-2349. J. Appl. Microbiol. 2019, 126, 1519–1529. [Google Scholar] [CrossRef]
- Chakraborty, K.; Kizhakkekalam, V.K.; Joy, M.; Chakraborty, R.D. Bacillibactin Class of Siderophore Antibiotics from a Marine Symbiotic Bacillus as Promising Antibacterial Agents. Appl. Microbiol. Biotechnol. 2022, 106, 329–340. [Google Scholar] [CrossRef]
- Liu, J.; Li, W.; Zhu, X.; Zhao, H.; Lu, Y.; Zhang, C.; Lu, Z. Surfactin Effectively Inhibits Staphylococcus aureus Adhesion and Biofilm Formation on Surfaces. Appl. Microbiol. Biotechnol. 2019, 103, 4565–4574. [Google Scholar] [CrossRef]
- Duca, D.; Lorv, J.; Patten, C.L.; Rose, D.; Glick, B.R. Indole-3-Acetic Acid in Plant–Microbe Interactions. Antonie Van Leeuwenhoek 2014, 106, 85–125. [Google Scholar] [CrossRef]
- Keswani, C.; Singh, S.P.; Cueto, L.; García-Estrada, C.; Mezaache-Aichour, S.; Glare, T.R.; Borriss, R.; Singh, S.P.; Blázquez, M.A.; Sansinenea, E. Auxins of Microbial Origin and Their Use in Agriculture. Appl. Microbiol. Biotechnol. 2020, 104, 8549–8565. [Google Scholar] [CrossRef]
- Wu, W.; Du, K.; Kang, X.; Wei, H. The Diverse Roles of Cytokinins in Regulating Leaf Development. Hortic. Res. 2021, 8, 118. [Google Scholar] [CrossRef]
- Arkhipova, T.N.; Veselov, S.U.; Melentiev, A.I.; Martynenko, E.V.; Kudoyarova, G.R. Ability of Bacterium Bacillus subtilis to Produce Cytokinins and to Influence the Growth and Endogenous Hormone Content of Lettuce Plants. Plant Soil 2005, 272, 201–209. [Google Scholar] [CrossRef]
- Park, Y.-G.; Mun, B.-G.; Kang, S.-M.; Hussain, A.; Shahzad, R.; Seo, C.-W.; Kim, A.-Y.; Lee, S.-U.; Oh, K.Y.; Lee, D.Y.; et al. Bacillus aryabhattai SRB02 Tolerates Oxidative and Nitrosative Stress and Promotes the Growth of Soybean by Modulating the Production of Phytohormones. PLoS ONE 2017, 12, e0173203. [Google Scholar] [CrossRef]
- Zaid, D.S.; Cai, S.; Hu, C.; Li, Z.; Li, Y. Comparative Genome Analysis Reveals Phylogenetic Identity of Bacillus velezensis HNA3 and Genomic Insights into Its Plant Growth Promotion and Biocontrol Effects. Microbiol. Spectr. 2022, 10, e02169-21. [Google Scholar] [CrossRef]
- Nascimento, F.X.; Hernández, A.G.; Glick, B.R.; Rossi, M.J. Plant Growth-Promoting Activities and Genomic Analysis of the Stress-Resistant Bacillus megaterium STB1, a Bacterium of Agricultural and Biotechnological Interest. Biotechnol. Rep. 2019, 25, e00406. [Google Scholar] [CrossRef]
- Andreolli, M.; Lampis, S.; Zapparoli, G.; Angelini, E.; Vallini, G. Diversity of Bacterial Endophytes in 3 and 15 Year-Old Grapevines of Vitis vinifera Cv. Corvina and Their Potential for Plant Growth Promotion and Phytopathogen Control. Microbiol. Res. 2016, 183, 42–52. [Google Scholar] [CrossRef]
- Ma, L.; Cao, Y.H.; Cheng, M.H.; Huang, Y.; Mo, M.H.; Wang, Y.; Yang, J.Z.; Yang, F.X. Phylogenetic Diversity of Bacterial Endophytes of Panax notoginseng with Antagonistic Characteristics towards Pathogens of Root-Rot Disease Complex. Antonie Van Leeuwenhoek 2013, 103, 299–312. [Google Scholar] [CrossRef]
- Liu, H.; Fu, G.; Li, Y.; Zhang, S.; Ji, X.; Qiao, K. Biocontrol Efficacy of Bacillus methylotrophicus TA-1 Against Meloidogyne Incognita in Tomato. Plant Dis. 2023, 107, 2709–2715. [Google Scholar] [CrossRef]
- Shan, H.; Zhao, M.; Chen, D.; Cheng, J.; Li, J.; Feng, Z.; Ma, Z.; An, D. Biocontrol of Rice Blast by the Phenaminomethylacetic Acid Producer of Bacillus methylotrophicus Strain BC79. Crop Prot. 2013, 44, 29–37. [Google Scholar] [CrossRef]
- Nagarajkumar, M.; Bhaskaran, R.; Velazhahan, R. Involvement of Secondary Metabolites and Extracellular Lytic Enzymes Produced by Pseudomonas fluorescens in Inhibition of Rhizoctonia solani, the Rice Sheath Blight Pathogen. Microbiol. Res. 2004, 159, 73–81. [Google Scholar] [CrossRef]
- Zhao, Y.; Selvaraj, J.N.; Xing, F.; Zhou, L.; Wang, Y.; Song, H.; Tan, X.; Sun, L.; Sangare, L.; Folly, Y.M.E.; et al. Antagonistic Action of Bacillus Subtilis Strain SG6 on Fusarium graminearum. PLoS ONE 2014, 9, e92486. [Google Scholar] [CrossRef]
- Shakil, S.; Khan, R.; Zarrilli, R.; Khan, A.U. Aminoglycosides versus bacteria–a description of the action, resistance mechanism, and nosocomial battleground. J. Biomed. Sci. 2008, 15, 5–14. [Google Scholar] [CrossRef]
- Macinga, D.R.; Rather, P.N. The chromosomal 2′-N-acetyltransferase of Providencia stuartii: Physiological functions and genetic regulation. Front. Biosci. 1999, 4, D132–D140. [Google Scholar] [CrossRef]
- Fong, D.H.; Xiong, B.; Hwang, J.; Berghuis, A.M. Crystal structures of two aminoglycoside kinases bound with a eukaryotic protein kinase inhibitor. PLoS ONE 2011, 6, e19589. [Google Scholar] [CrossRef]
- Stogios, P.J.; Kuhn, M.L.; Evdokimova, E.; Law, M.; Courvalin, P.; Savchenko, A. Structural and biochemical characterization of Acinetobacter spp. aminoglycoside acetyltransferases highlights functional and evolutionary variation among antibiotic resistance enzymes. ACS Infect Dis. 2017, 3, 132–143. [Google Scholar] [CrossRef]
- Fajardo, A.; Martínez-Martín, N.; Mercadillo, M.; Galán, J.C.; Ghysels, B.; Matthijs, S.; Cornelis, P.; Wiehlmann, L.; Tümmler, B.; Baquero, F.; et al. The neglected intrinsic resistome of bacterial pathogens. PLoS ONE 2008, 3, e1619. [Google Scholar] [CrossRef]
- Cox, G.; Wright, G.D. Intrinsic antibiotic resistance: Mechanisms, origins, challenges and solutions. Int. J. Med. Microbiol. 2013, 303, 287–292. [Google Scholar] [CrossRef]
- Wright, G.D. The antibiotic resistome: The nexus of chemical and genetic diversity. Nat. Rev. Microbiol. 2007, 5, 175–186. [Google Scholar] [CrossRef]
- Hu, Y.; Gao, G.F.; Zhu, B. The antibiotic resistome: Gene flow in environments, animals and human beings. Front. Med. 2017, 11, 161–168. [Google Scholar] [CrossRef] [PubMed]
- Nikaido, H. Multidrug resistance in bacteria. Annu. Rev. Biochem. 2009, 78, 119–146. [Google Scholar] [CrossRef] [PubMed]

| Pathogens | Erwinia billingiae | Pantoae agglomerans | Xantomonas campestris |
|---|---|---|---|
| Area of inhibition (mm) | 4.33 ± 0.33 | 3.66 ± 0.33 | 1.66 ± 0.33 |
| AMR25 | N2B2 | FZB42 | DMS7 | 168 | |
|---|---|---|---|---|---|
| Genome size (bp) | 3,909,646 | 3,953,520 | 3,918,589 | 3,980,199 | 4,214,630 |
| G+C content (mol%) | 46.6% | 46.6% | 46.4% | 46.1% | 43.5% |
| Number of protein-coding sequences | 3716 | 3886 | 3693 | 3921 | 4106 |
| Average CDS size (bp) | 923 | 925 | 933 | 888 | 895 |
| Percentage of coding regions | 88.50% | 88% | 88% | 87% | 87% |
| Number of tRNA | 86 | 65 | 89 | 94 | 86 |
| Number of rRNA operons | 9 | 1 | 10 | 10 | 10 |
| IS elements | 2 | 2 | 9 | n.r. | 0 |
| Phage-associated genes | 47 | 108 | 44 | 185 | 268 |
| Region (Figure 6) | Metabolite | Most Similar Known Cluster | Size, Kb | Bioactive Spectrum | Similarity |
|---|---|---|---|---|---|
| 1 | Andalusicin A/B | RiPP: Lanthipeptide | 83.1 | Inhibits the growth of Gram-positive bacteria [44] | 100% |
| 2 | Surfactin | NRP: Lipopeptide | 64.8 | Cochliobolus carbonum; Pseudomonas syringae pv. tomato Ralstonia solanacearum; Fusarium verticillioides [45,46] | 82% |
| 5 | Macrolactin H | Polyketide | 87.8 | Staphylococcus aureus; Burkholderia cepacia [47] | 100% |
| 6 | Bacillaene | Polyketide + NRP | 81.7 | Erwinia amylovora [48] | 85% |
| 7 | Fengycin | NRP | 136.8 | R. solanacearum; Xanthomonas euvesicatoria; F. oxysporum; F. graminearum; Botrytis cinerea [49,50,51] | 100% |
| 10 | Difficidin | Polyketide | 93.8 | X. oryzae pv. oryzae; E. amylovora; R. solanacearum [46] | 100% |
| 11 | Bacillibactin | NRP | 51.8 | S. aureus; Enterococcus faecalis; Klebsiella pneumonia [52] | 100% |
| 12 | Bacilysin | Other | 41.4 | S. aureus; X. oryzae pv. oryzae; E. amylovora [46] | 100% |
| Antibiotic | Disk Concentration (µg/mL) | Area Diam (mm) | Category |
|---|---|---|---|
| Penicillins | |||
| Amoxicillin | 10 | 0 | R |
| Oxacillin | 1 | 0 | R |
| Penicillin | 10 | 7 | R |
| Cephems | |||
| Cefoperazone | 75 | 12 | R |
| Ceftazidime | 30 | 0 | R |
| Macrolides | |||
| Azithromycin | 10 | 13 | R |
| Erythromycin | 15 | 14 | R |
| Oleandomycin | 15 | 1 | R |
| Fluoroquinolones | |||
| Levofloxacin | 5 | 18 | S |
| Aminoglycoside | |||
| Gentamicin | 10 | 9 | R |
| Glycopeptides | |||
| Vancomycin | 30 | 13 | I |
| Tetracyclines | |||
| Tetracycline | 30 | 12 | R |
| Accession | Start | Stop | Orientation | Gene Name | Resistance Mechanism | Drug Class |
|---|---|---|---|---|---|---|
| ARO: 3002972 | 509,896 | 511,065 | + | vanT | antibiotic target alteration | glycopeptide antibiotic |
| ARO: 3002814 | 565,150 | 566,199 | + | clbA | antibiotic target alteration | lincosamide antibiotic; streptogramin antibiotic; oxazolidinone antibiotic; phenicol antibiotic; pleuromutilin antibiotic |
| ARO: 3002877 | 1,195,572 | 1,196,486 | + | BcI | antibiotic inactivation | cephalosporin; penem |
| ARO: 3007014 | 1,811,775 | 1,812,128 | − | qacJ | antibiotic efflux | disinfecting agents and antiseptics |
| ARO: 3002956 | 2,087,420 | 2,088,238 | − | vanY | antibiotic target alteration | glycopeptide antibiotic |
| ARO:3002818 | 2,124,728 | 2,125,162 | − | msrB | antibiotic target protection | streptogramin antibiotic, macrolide antibiotic |
| ARO:3000251 | 2,125,164 | 2,125,697 | − | msrA | antibiotic target protection | streptogramin antibiotic, macrolide antibiotic |
| ARO:3004958 | 2,175,434 | 2,178,217 | + | ponA | antibiotic target alteration | penicillin antibiotic |
| ARO: 3003196 | 2,554,632 | 2,556,008 | − | tet(45) | antibiotic efflux | tetracycline antibiotic |
| ARO: 3007015 | 3,883,659 | 3,884,042 | − | qacG | antibiotic efflux | disinfecting agents and antiseptics |
| Pathogens | Alternaria tenuissima | Botrytis cinerea | Fusarium avenacea |
|---|---|---|---|
| Inhibition Index (%) | 65.71 ± 1.48% | 71.72 ± 1.48% | 62.86 ± 1.48% |
Disclaimer/Publisher’s Note: The statements, opinions and data contained in all publications are solely those of the individual author(s) and contributor(s) and not of MDPI and/or the editor(s). MDPI and/or the editor(s) disclaim responsibility for any injury to people or property resulting from any ideas, methods, instructions or products referred to in the content. |
© 2024 by the authors. Licensee MDPI, Basel, Switzerland. This article is an open access article distributed under the terms and conditions of the Creative Commons Attribution (CC BY) license (https://creativecommons.org/licenses/by/4.0/).
Share and Cite
Ananev, A.A.; Ogneva, Z.V.; Nityagovsky, N.N.; Suprun, A.R.; Kiselev, K.V.; Aleynova, O.A. Whole Genome Sequencing of Bacillus velezensis AMR25, an Effective Antagonist Strain against Plant Pathogens. Microorganisms 2024, 12, 1533. https://doi.org/10.3390/microorganisms12081533
Ananev AA, Ogneva ZV, Nityagovsky NN, Suprun AR, Kiselev KV, Aleynova OA. Whole Genome Sequencing of Bacillus velezensis AMR25, an Effective Antagonist Strain against Plant Pathogens. Microorganisms. 2024; 12(8):1533. https://doi.org/10.3390/microorganisms12081533
Chicago/Turabian StyleAnanev, Alexey A., Zlata V. Ogneva, Nikolay N. Nityagovsky, Andrey R. Suprun, Konstantin V. Kiselev, and Olga A. Aleynova. 2024. "Whole Genome Sequencing of Bacillus velezensis AMR25, an Effective Antagonist Strain against Plant Pathogens" Microorganisms 12, no. 8: 1533. https://doi.org/10.3390/microorganisms12081533
APA StyleAnanev, A. A., Ogneva, Z. V., Nityagovsky, N. N., Suprun, A. R., Kiselev, K. V., & Aleynova, O. A. (2024). Whole Genome Sequencing of Bacillus velezensis AMR25, an Effective Antagonist Strain against Plant Pathogens. Microorganisms, 12(8), 1533. https://doi.org/10.3390/microorganisms12081533

